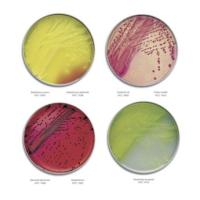
Culture Media Plates

Culture Media
Culture media contain nutrients and physical growth parameters necessary for microbial growth. All microorganisms cannot grow in a single culture medium and in fact, many cannot grow in any known culture medium. Many special-purpose media are needed to facilitate recognition, enumeration, and isolation of certain types of bacteria. That is why The Lab Depot offers a wide variety of culture media for use in your next microbiological study, We offer many culture media and also market specific culture media, such as, clinical culture, cosmetic culture, dairy culture, food and beverage culture, veterinary, and water/waste culture. We distribute the best quality and ISO-9001 certified to meet all of the most intensive regulatory needs.
Culture Media
Our values at The Lab Depot include customer commitment, excellence, honesty, and integrity. These values help us strive to be the best in the business. Choose the best supplies for your company or lab. Look through our wide variety of culture media. If you have any questions, contact one of our live customer service representatives.